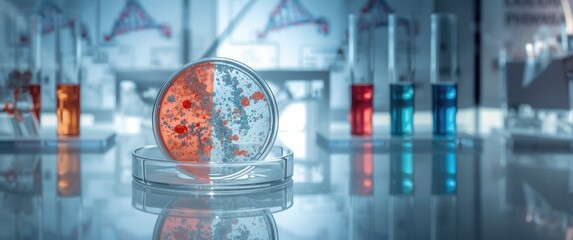
Electrophoresis image of DNA sequence, restriction map, Petri dish, and tubes

- Home >
- Stock Photos >
- Digital DNA Sequence Overlaying Dynamic World Map
Digital DNA Sequence Overlaying Dynamic World Map Image

This digital illustration features a blue DNA strand overlaying a world map with a green gradient background, symbolizing the intersection of global medical research and advanced technology. Ideal for presentations on biotechnology, genetic research, or global health initiatives. Suitable for illustrating articles about the latest trends in the field of genetics and international scientific collaboration.
downloads
Tags:
More
Credit Photo
If you would like to credit the Photo, here are some ways you can do so
Text Link
photo Link
<span class="text-link">
<span>
<a target="_blank" href=https://pikwizard.com/photo/digital-dna-sequence-overlaying-dynamic-world-map/96a585ce7e5b532b22fb7401f757c61b/>PikWizard</a>
</span>
</span>
<span class="image-link">
<span
style="margin: 0 0 20px 0; display: inline-block; vertical-align: middle; width: 100%;"
>
<a
target="_blank"
href="https://pikwizard.com/photo/digital-dna-sequence-overlaying-dynamic-world-map/96a585ce7e5b532b22fb7401f757c61b/"
style="text-decoration: none; font-size: 10px; margin: 0;"
>
<img src="https://pikwizard.com/pw/medium/96a585ce7e5b532b22fb7401f757c61b.jpg" style="margin: 0; width: 100%;" alt="" />
<p style="font-size: 12px; margin: 0;">PikWizard</p>
</a>
</span>
</span>
Free (free of charge)
Free for personal and commercial use.
Author: Creative Art